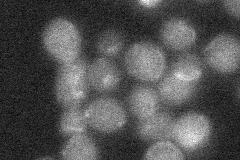
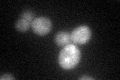

View description
Putative transcription factor involved in regulating the response to osmotic stress; member of the MADS-box family of transcription factors
Localization:
Intensity:
Fold change:
Significance:
-
C’ GFP library in SD

punctate33.63 -
N' NOP1pr-GFP in SD

nucleus32.0133 -
N' TEF2pr-mCherry in SD

nucleus63.9162 -
N' NATIVEpr-GFP in SD
punctate19.8428 -
N' TEF2pr-VC and Cyto-VN in SD

below threshold23.9038 -
C’ GFP library in SD+DTT
punctate24.70.73No -
C’ GFP library in SD+H2O2

punctate33.60.99No -
C’ GFP library in Starvation Media

punctate19.310.57Yes -
C’ GFP library on the background of Pup2-DaMP

punctate -
C’ GFP library on the background of CCT mutant

punctate32.54310.967594No
